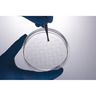

Dischi confocali
JetBiofil
Provette filtranti Jet Biofil
JetBiofil

Filtri sterili per siringa Jet Biofil
JetBiofil

Complessi filtranti in PES JetBiofil
JetBiofil

Cell scraper Jet Biofil
JetBiofil

Piastra multipozzetto Jet Biofil
JetBiofil
Sinonimi
: Micropiastra

Flask Jet Biofil
JetBiofil

Roller bottle Jet Biofil
JetBiofil

Bottiglia per Soluzioni
JetBiofil

Pipetta sierologica mini in plastica
JetBiofil

Provetta conica 225 mL
JetBiofil
Sinonimi
: Tubi per centrifuga

Contenitore per reattivi Jet Biofil
JetBiofil

Sinonimi
: Micropiastre multipozzetto
Piastra Petri JET CellSLIP Cell slide
JetBiofil
Sinonimi
: Capsula Petri , Scatola Petri

Piastra a 6 pozzetti JET CellSCAFFOLD 3D
JetBiofil

Sinonimi
: filtri cellulari

Sinonimi
: Scatola Petri , Capsula Petri
Aggiunto al tuo carrello
Disponibilità del prodotto per posizione del negozio
Ore